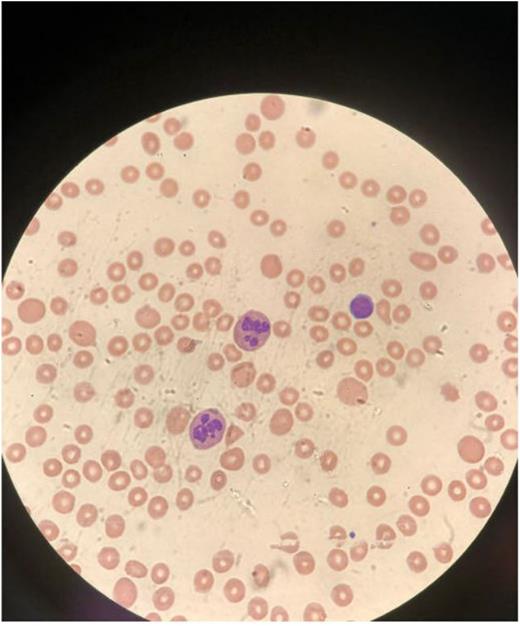
Figure 1

Abstract
Introduction: Macrocytic anemia can be associated with chronic alcohol use, vitamin B12 and folic acid deficiency. However, it is very uncommon to see severe anemia in developed world, especially in a young healthy patient without any medical issues. Folate deficiency is rarely reported to cause hemolytic anemia. We present an interesting case report of a young female with severe anemia from vitamin B12, folate deficiency and nonimmune intramedullary hemolysis.
Case: 40-year-old Caucasian female with no significant past medical history, who has not seen a doctor in the last 20 years presented to our emergency department complaining of worsening shortness of breath and bilateral lower limb swelling for the last 6 months prior to admission. Shortness of breath had been worsening in the last 2 months to a point that she can barely walk about 6 feet. Patient also reported non-bloody diarrhea for the last few weeks, reports looking pale by her coworkers. She is a nonsmoker, drinks about 2 drinks a day, no illicit drug use and works as a state trooper police officer. Patient had stable vital signs with tachycardia of heart rates in 90s, physical exam showed scleral icterus and pallor and 2 + bilateral lower limb pitting edema. Blood work showed hemoglobin 2.2 mg/dl, hematocrit 6.9, MCV 153.3, MCH 48.9, MCHC 31.9, platelet count 62, reticulocyte 2.1%, low vitamin B12 of 159pg/ml, low serum folate, elevated LDH and low haptoglobin. Negative direct combs test, Negative Celiac antibodies, normal iron panel, negative HIV, hepatitis A, B and C serologies, EBV, normal methylmalonic acid level, elevated homocysteine level, negative PNH panel. Patient had a normal EGD and colonoscopy, and negative stool studies including C.diff, shigella, salmonella, vibrio, and E.coli. Patient received 5 units of packed red blood cells and 1 unit of FFP. Hemoglobin improved with 5 units packed red blood cells, IV folic acid and IM vitamin B12 injections. Patient was discharged home on oral folic acid and vitamin B 12 replacement.
Conclusion: Severe anemia from isolated folate and vitamin B 12 although uncommon in young healthy patients but should be considered in the differential diagnosis.
Intramedullary hemolysis is a rare presentation of severe folate deficiency with limited literature.
Disclosures
No relevant conflicts of interest to declare.
Author notes
Asterisk with author names denotes non-ASH members.